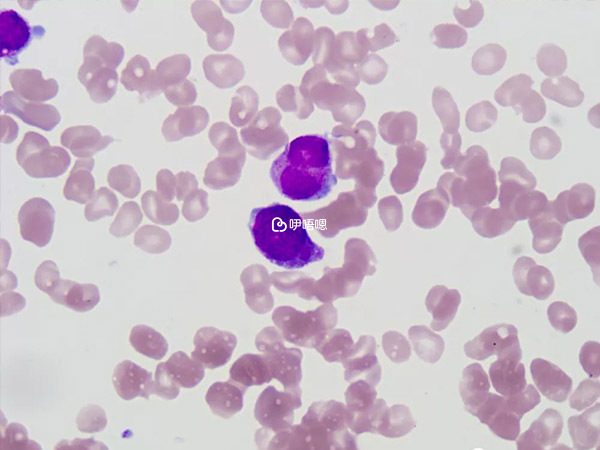

16年我和我老婆散婚,我和我老婆同齡都是92年的,結婚的時候也不算年紀大,所以婚後一直也不著急要孩子,本著順其自然的原則備孕了大半年卻依舊了無音訊。這時候家裡的父母開始不淡定了,因出於對父母的歉意和也自認為自己也可以為人父母的心情,於是便帶著老婆在蘇州檢查了幾次,結果都被告知沒有問題,醫生讓慢慢等待即可

然而一晃眼又是大半年過去了,零零散散的檢查做了不少,備孕的知識也懂了很多,甚至連好懷孕的體位都做了功課,就連中藥都喝了一包又一包,結果一樣是石沉大海,毫無波瀾!
萬念俱灰的情況下又在家裡的擔憂中直接奔赴上海做全面檢查,第一站來到了上海紅房子,來之前我老婆還和我吵了一架,說我全家人懷疑她不能生孩子懷疑她有病……我說也不一定懷疑你指不定也是我的問題呢!
就這樣帶著不愉快的心情來到了上海紅房子全面檢查後發現我老婆雙側輸卵管積水,醫生安慰這個不是大事,做個手術疏通以後還是可以自然懷孕,我老婆當時嚇的驚慌失措,為了證明這是誤診我們又去了上海婦嬰結果更嚴重直接造影說我老婆輸卵管天生硬化,自然懷孕的概率幾乎為零!
就這樣我們從信心滿滿的可以自己懷孕到需要手術後再懷孕再到只能通過試管才可能懷孕的三重打擊。我老婆從此變得多疑敏感、脾氣越來越暴躁了,但是前途漫漫,即使困惑迷茫,可是路還是要往前走。
經過家人的支援和安慰我們最終還是走上了試管這條漫長又黑暗且折磨人的道路上。這一路走來有爭吵,有謾罵有不甘心有憤恨不平,也有驚喜、酸甜苦辣百味人生。17年國慶後我們正式踏上了試管路,奔赴上海仁濟第一步就是促排。

打針吃藥測卵泡,激素藥吃的我老婆都水腫,同事都笑話她變胖了,但是隻有她自己知道為什麼,一個恐針的女孩子到後來自己給自己注射針劑,一切都是逼出來的,媽媽這個詞太重,讓女人吃的苦太多。
幸運的是第一步我們很成功,卵泡發育良好,雖然我老婆有多囊但是後期的精卵結合還是結果很讓人滿意。12個胚胎,4凍8囊,出乎我們的期望,心裡又多了絲陽光,因為我老婆取卵過多不適合移植鮮胚,所以我們休息了一個多月後開始了我們的第一次移植。
因為我老婆有雙側輸卵管積水,醫生想試一把碰碰運氣,再沒有做輸卵管結紮的前提下移植了兩枚凍胚,結果可想而知我們不幸移植失敗了!我當時安慰老婆我們胚胎還有很多會有成功的,帶著沉重的心情不得不接受事實。
就這樣我們休息了一個多月後又開始了第二次移植,家裡面糾結是否結紮輸卵管,父母自然意思保留輸卵管萬一以後有奇蹟我們還能自己生一個,可是世上哪有那麼多奇蹟呢?然後為了再賭一次又選擇了直接移植沒有處理結紮輸卵管,後來自然還是再次移植失敗,這次是兩囊結果也浪費了兩個優質胚胎,實在可惜。
經過了兩次的移植失敗我們不敢在冒然行動,一是多次試管失敗對我老婆傷害極大的,不管身體和心理都要承受過多的壓力。二是治療費太貴我們普通老百姓賭不起也耗不起,所以最後開了個家庭會議最終決定聽取醫生建議直接結紮輸卵管,提高移植成功率。

可惜好事多磨原以為做個結紮手術就好,誰知道手術中又被告知我老婆輸卵管已經硬化壞死有一個都爛的快斷掉了,最後決定一邊切除一邊結紮,手術很成功,但是術後又被告知檢驗手術標本我老婆被懷疑有結核可以,真的是運氣不好喝水都塞牙。
本來以為一切終算撥開雲霧見青天了,誰知道半路又給你整個結合可能,好吧!兵來將擋,水來土掩,又開始了結核醫院的來回奔赴檢查。幸運的是結果一切正常還沒有我們預期的嚴重可以暫時準備懷孕了,聽到這個我老婆開心了好幾天。
我們終於熬到了今年的10月7日,這是個特殊的日子,那天上海下著毛毛雨,一切壓抑又顯得過於沉悶,那是我老婆的第三次移植。經過了中途各種坎坷和曲折她信心明顯不足,那段時間是即緊張又敏感,還帶點悲觀色彩。中途因為我忙的忘了做飯給她吃,她還摔碗跟我大吵了一架。
第六天的早上迷迷糊糊睡夢裡被我老婆神神祕祕的叫醒讓我看她測的大衛試紙,隱隱約約我看到了那一絲灰印。激動之餘又怕是咋胡鬧烏龍,夫妻兩神經質的對著一個驗孕紙研究了四個小時,我老婆問我是否看到灰印確認了七八次。
後來隨著時間一天一天推移,試紙顏色越來越深,我們終於耐不住性子去醫院抽血檢查結果懷孕了!心裡面開心的飛了,但是表面還要故作鎮定,不能太得瑟也不能太炫耀,這是神賜的,所以我要低調。路還漫長二百多天的日子我們還要一天天熬,各個檢查還要一個個闖,14天血值直奔1100,終算心理踏實了。

後來隔個兩三天就要抽血看翻倍看黃體酮看雌二醇,每一個環節和引數我們都必須密切關注,我老婆為了這次一定成功又開始了保胎之路。打達肝素,打立生素,吃環孢素,家裡藥一堆,一日三頓不敢停頓,可是即使這樣還是一直有出血現象。
老婆最後毅然選擇打針取代塞雪諾酮,可是沒過幾天也就是上週三,因為打立生素和達肝素晚上九點突然大出血,去當地醫院檢查白細胞直接飆升38萬,醫生也不知如何下手只能讓我們回家第二天再去檢查。
可是我們怎麼敢坐以待斃,這孩子來的太不容易了我決定請假直接還是奔赴上海,到了上海掛個急診檢查相關血液後,依舊發現白細胞高的驚人。醫生一時間還以為我老婆得了白血病,後來瞭解了我老婆的用藥史後才算找出病因。
原來是我老婆打了立生素的原因,才導致出血且白細胞異常增高,經過停藥住院觀察幾天後總算風平浪靜了,但是前一天B超發現孕囊偏左側,醫生還是不放心。雖然其他指標暫時正常可是孕囊偏左也是個問題,目前也只能繼續住院觀察,真心希望瓜娃子讓你媽輕鬆點吧!
為了你我們年紀輕輕承受了好多,別人還在秀恩愛我們卻還在擔心你的健康和平安。二百多天的等待和期盼是一日一日的熬著,希望你能茁壯成長開心快樂又健康。至於男孩女孩都不重要,爸媽只要你不要鬧騰了安安穩穩的好好的長大,趕快游回正中間的位置,少讓你媽媽擔心受怕了!這一路太累了,讓你爹媽歇歇可好?
這一天天心情就像過山車,看你來了喜出天外,看有出血嚇得驚慌失措語無倫次,好不容易安穩了幾天你有孕囊偏左,操不完的心,這淘氣孩子爸媽求你好好的游到正中間我們期待你一天天的成長,加油哦寶寶,爸媽期待與你早日全家團圓,這是我19年最大的心願,希望大夥給我們點正能量給我寶寶加加油,加油!
基本資訊來自醫院官網或醫院內公示資訊或醫生本人提供,如有侵權,請按照平臺提供的渠道通知